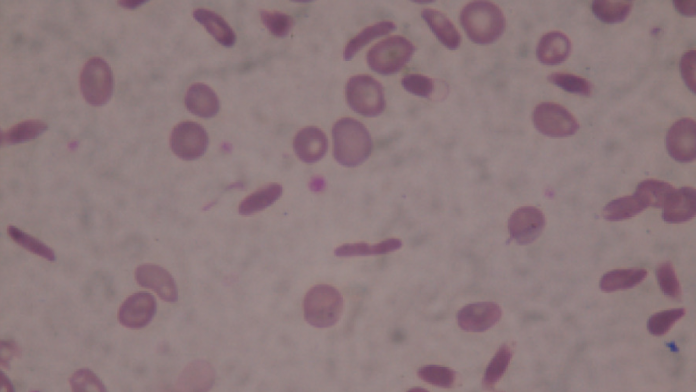
Investigadores de la UIB proponen una nueva metodología de IA para mejorar el diagnóstico de la drepanocitosis

Un equipo de investigadores de la Universitat de les Illes Balears (UIB) ha desarrollado una metodología innovadora para mejorar la generalización de los modelos de inteligencia artificial aplicados al diagnóstico de la drepanocitosis, una enfermedad también conocida como anemia de células falciformes, a partir de imágenes microscópicas de glóbulos rojos.
22 de enero de 2026. El sistema, impulsado por investigadores de la Unidad de Gráficos y Visión por Ordenador e Inteligencia Artificial (UGiVIA) y del Laboratorio de Aplicaciones de Inteligencia Artificial de la UIB (LAIA@UIB), prioriza la robustez, la fiabilidad y la interpretabilidad de los modelos de IA, aspectos clave para su aplicación en entornos clínicos diversos, especialmente en contextos con recursos limitados.
La propuesta se basa en el uso del aprendizaje conjunto (ensemble learning), una técnica que combina diferentes modelos de aprendizaje automático para mejorar la clasificación morfológica de las células. Este enfoque permite seleccionar los atributos más relevantes, reducir la complejidad del sistema y acortar el tiempo de entrenamiento, sin renunciar a una buena capacidad de generalización.
El sistema parte de un preprocesamiento y segmentación cuidadosos de las imágenes, con el objetivo de extraer características de alta calidad. Posteriormente, se aplican modelos basados en Random Forest y Extra Trees, que han alcanzado un F1-score del 90,71 % y un índice específico de apoyo al diagnóstico (SDS-score) del 93,33 %, superando los resultados obtenidos con modelos de Gradient Boosting, que registraron valores inferiores.
Estos resultados suponen un avance significativo respecto al estado del arte, especialmente en términos de generalización y fiabilidad de los modelos de inteligencia artificial aplicados al diagnóstico médico.
Con el objetivo de fomentar la transparencia y la replicabilidad científica, el equipo investigador ha puesto a disposición de la comunidad los parámetros de los modelos, el código implementado y las matrices de confusión con los datos en bruto.
En el estudio han participado los investigadores del Departamento de Ciencias Matemáticas e Informática de la UIB Gabriel Moyà Alcover, miembro de UGiVIA y LAIA@UIB; Jose Maria Buades Rubio, de UGiVIA; y Antoni Jaume-i-Capó, investigador de UGiVIA y director del LAIA@UIB.